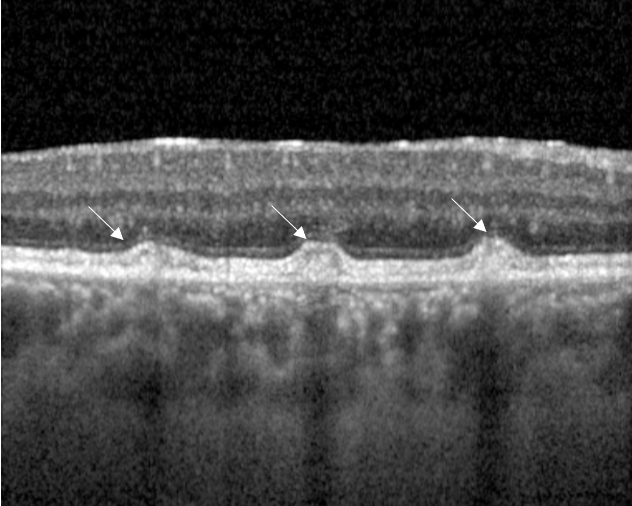

Maladie de Stargardt / Fundus Flavimaculatus

Qu’est ce que la Maladie de Stargardt ?
La maladie de Stargardt est une atteinte rare (incidence inférieure à 1/2 000) de la macula (centre de la rétine). Il s’agit d’une dystrophie des cônes héréditaire, affectant les patients avant l’âge de 20 ans, avec une perte brutale de la vision centrale. Il existe une forme adulte appelé Fundus Flavimaculatus qui survient entre 20 et 60 ans, et évolue plus lentement.
Cette pathologie est génétique. Elle est dû à une mutation d’un gène sur le chromosome 1.



Quels sont les symptômes de la Maladie de Stargardt ?
La baisse de la vision est bilatérale et non réversible mais ne rend pas aveugle. L’atteinte reste centrale, avec la présence d’un scotome (tache sombre), empêchant la lecture fine. La vision périphérique est conservée. Les déplacements restent possibles. La vision de certaines couleurs (rouge et vert) est perturbée. Il y a une baisse de contraste importante en basse luminosité et vision nocturne.

En quoi consiste le dépistage de la maladie de Stargardt ?
Le motif de la consultation est souvent une baisse rapide de la vision. Le bilan débute avec la mesure de l’acuité visuelle par l’orthoptiste pour quantifier cette gêne.
Seul un bilan d’imagerie multimodale permet de poser le diagnostique. A savoir, l’OCT* (Tomographie à cohérence optique) de la macula, des rétinophotos couleurs et auto fluorescentes, la réalisation d’une angiographie à la fluorescéine*. D’autres examens tels que l’ERG (éléctrorétinogramme) ou un bilan génétique peu être prescrit lors de la consultation.
Un conseil génétique est encouragé. Le risque de récurrence doit être évoqué. Les principes du diagnostic prénatal sont exposés. Il s’agit d’un prélèvement sanguin qui pose le diagnostique moléculaire.

Quel est le traitement de la Maladie de Stargardt ?
Il n’existe actuellement aucun traitement validé pour améliorer ou ralentir l’évolution de cette dystrophie. Néanmoins il est recommandé aux patients de se protéger des UV, par le port de verres teintés. Les compléments alimentaires riche en vitamine A ou bêta carotène sont à proscrire.
Pour aider les patients au quotidien, des séances de rééducation orthoptique dites « basse vision » permettent aux patients d’utiliser de façon optimal leur champ visuel périphérique. Il existe également des aides optiques (filtres de type Lumior 2 à l’intérieur, ORMA RT3 à l’extérieur, agrandisseurs etc…).
Des aides non optiques peuvent également améliorer le quotidien des patients, tels que des livres imprimés en gros caractères, des cartes à jouer avec de gros numéros, montre parlante, téléphone à grosses touches…

